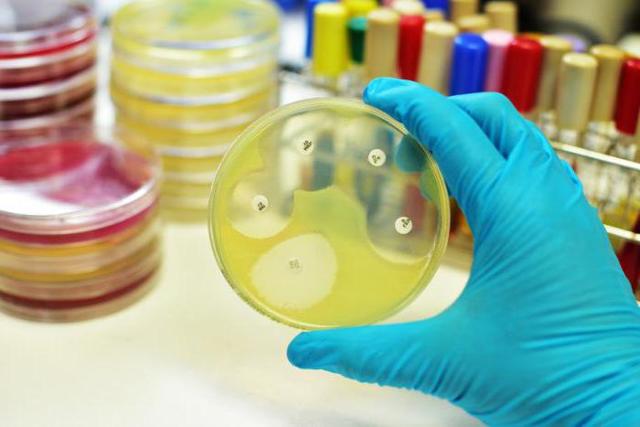
Нолицин: инструкция по применению и для чего он нужен, цена, отзывы, аналоги

Антибактериальное средство «Нолицин» является торговым названием «Норфлоксацина» — изделия, относящегося к классу фторхинолонов. Этот медикамент отличается таблетированной формой выпуска. Его производит словенская фармацевтическая фирма «КРКА». Стоимость этого лекарственного изделия составляет около трехсот пятидесяти рублей.

К таблеткам «Нолицин» инструкция по применению и отзывы будут представлены ниже.
Является ли препарат антибиотиком?
Он выступает антибиотиком, который относится к группе грамфторхинолонов второго поколения. Активным компонентом «Нолицина» служит, как уже отмечалось, норфлоксацин.
Его принципиальное отличие от прочих фторхинолоновых антибиотиков второго поколения кроется в том, что он создает заметные бактерицидные концентрации исключительно в районе пищеварительной системы, а также в мочеполовых путях.
В статье, кроме инструкции по применению, отзывы, цены аналогов, цена «Нолицина» также будут представлены.
От чего способен помочь медикамент?
Этот препарат особенно эффективен в борьбе со стафилококками, включая метициллиночувствительные штаммы, а, кроме того, с гонококками, менингококками, цитробактериями, клебсиеллами, сальмонеллой, шигеллами, холерной вибрионой, гемофильной палочкой, хламидиями и легионеллами.
Небольшой чувствительностью к действию норфлоксацина обладают энтерококки наряду со стрептококками, микоплазмами, микобактериями и псевдомонадами.
Полностью резистентными к воздействию антибиотика выступают уреаплазмы, пептострептококки, бактероиды, фузобактерии, пептококки, клостридии и трепонемы.
Отзывы о «Нолицине» имеются в большом количестве.
Состав антибактериального средства
Активным веществом в данном случае является норфлоксацин. К вспомогательным ингредиентам относятся: натрий, диоксид кремния, стеарат магния, очищенная для гидрации вода, повидон и карбоксиметилкрахмал. Оболочка препарата изготовлена из гипромеллозы, диоксида титана, желтого красителя Е110, талька и пропиленгликоля.
Фармакологическое воздействие препарата на организм человека
Компонент норфлоксацин имеет выраженный бактерицидный механизм антибактериальной активности, который реализуется за счет связи с ДНК-гиразой, а также благодаря ингибированию дезоксирибонуклеиновой кислоты бактерий.
Эта связь может приводить к нарушению процессов сверхспирализации микробных цепочек соответствующих кислот, а также к дальнейшей дестабилизации и полному распаду на более мелкие элементы.
Это подтверждают к средству «Нолицин» инструкция по применению и отзывы. Цена интересует многих.
Норфлоксацин может хорошо усваиваться во время перорального приема, так как быстро достигает значимых терапевтических целей в мочеполовой и пищеварительной системе. В целях обеспечения полной всасываемости вещества его следует употреблять за час до или спустя сто двадцать минут после еды.
В том случае, если необходимо снизить риск развития появления нежелательных эффектов от использования «Нолицина», желательно употреблять не меньше двух литров воды в день. Процедура утилизации этого антибиотика из организма происходит преимущественно с мочой.
Небольшая доля норфлоксацина выходит с калом.
Антибиотик может проявлять бактерицидное воздействие, направленное против различных штаммов микроорганизмов.
Кроме того, за счет специфической структуры и степени активности норфлоксацин является эффективным в отношении бактерий, которые обладают устойчивостью к оксолиновой, налидиксовой и пипемидовой кислотам.
Штаммы различных микроорганизмов, которые обладают устойчивостью к норфлоксацину, являются резистентными и к этим препаратам.
В рамках использования норфлоксацина есть риск появления перекрестной устойчивости по отношению к другим изделиям фторхинолонового ряда.
Подобная резистентность возникает вследствие процессов мутации в генах бактерий, которые отвечают за кодирование дезоксирибонуклеиновой гиразы, то есть меняются мишени для воздействия фторхинолонов.
Кроме того, дополнительно к главной мутации вероятно изменение проницаемости мембраны бактериальных клеток для антибиотиков представленной группы.
По отзывам о «Нолицине», инструкция по применению очень подробная.

Показания к использованию
Отличаясь от прочих фторхинолоновых веществ, норфлоксацин способен создавать бактерицидные концентрации лишь в районе пищеварительных органов и мочеполовой системы.
Поэтому «Нолицин» можно использовать в целях лечения больных, страдающих инфекциями мочеполовой системы, включая неосложненную форму гонореи, шигеллез, сальмонеллез и диарею.
Кроме того, средство может использоваться для профилактики и предупреждения возникновения септических осложнений у пациентов с нейтропенией.
К препарату «Нолицин» цена и отзывы представлены в конце статьи.
Противопоказания к употреблению
Подобно другим препаратам фторхинолонового класса, «Нолицин» нельзя прописывать для лечения пациентов, которые еще не достигли совершеннолетнего возраста. Также «Нолицин» нельзя назначать женщинам, которые вынашивают ребенка либо кормят грудью.
Кроме того, данное лекарственное средство строго запрещается принимать в случае наличия:
- Гемолитической анемии.
- Тяжелой почечной недостаточности.
- Порфирии.
- Воспалений и разрывов сухожилий из-за приема фторхинолонов.
- Индивидуальной гиперчувствительности к фторхинолонам либо к вспомогательным элементам этого лекарственного препарата.

С особой осторожностью и лишь в случае крайней необходимости этот антибиотик можно назначать пациентам, страдающим тяжелым атеросклерозом, а, кроме того, приступами эпилепсии наряду с комбинированной формой почечно-печеночной недостаточности, равно как и при злокачественной миастении. Это указывает инструкция по применению. Цена «Нолицина», по отзывам, слегка завышена.
- Помимо этого, следует проявлять осторожность при назначении его людям, страдающим аритмиями и тахикардией, пациентам со снижением калия в крови, то есть при гипокалиемии, а также людям, которые получают лечение «Эритромицином» либо антипсихотическими препаратами наряду с трициклическими антидепрессантами.
- Норфлоксацин может влиять на скорость реакции, поэтому во время лечения не рекомендуется водить транспортное средство либо работать с опасными механизмами.
- О чем еще сообщается в инструкции и отзывах о «Нолицине»?
Использование при беременности
Абсолютно все препараты из категории фторхинолонов являются противопоказанными к применению женщинам, которые вынашивают ребенка. Строго проведенных исследований на предмет безопасности норфлоксацина для плода не было, в связи с чем «Нолицин» во время беременности может употребляться лишь по жизненно важным показаниям, при условии отсутствия более безопасной альтернативы.
Употребление препарата в рамках естественного вскармливания врачами тоже не назначается. В случае необходимости такого назначения обязательно необходимо перевести ребенка на искусственное кормление при применении «Нолицина». Отзывы на этот счет имеются.
Как следует принимать медикамент?
Для лечения неосложненных форм цистита употребляют по четыреста миллиграмм дважды в сутки, курсом от трех до пяти дней. В случае наличия острых инфекций мочевыводящих путей данное средство употребляют по полграмма каждые двенадцать часов. Продолжительность лечения составляет от семи до десяти дней.

Инструкция по применению «Нолицина» содержит информацию о том, что на фоне хронических и часто рецидивирующих инфекций мочевыводящих каналов продолжительность приема средства может доходить до двенадцати недель. При этом в первый месяц препарат принимают по четыреста миллиграмм каждые двенадцать часов, а затем по одной таблетке в день.
В целях лечения острых, а также неосложненных видов гонореи рекомендуется однократное употребление двух-трех таблеток «Нолицина». Цена, отзывы, аналоги представлены далее. Кроме того, при необходимости лекарство можно принимать по одной таблетке два раза в день и продолжать курс до одной недели.
На фоне инфекционных воспалений органов репродуктивной системы рекомендуется употреблять от 400 до 500 миллиграммов каждые двенадцать часов в течение недели. Пациентам с гастроэнтеритами бактериальной природы желательно использование средства в течение пяти дней по полграмма дважды в день.
В целях предупреждения возникновения диареи у путешественников принимают по одной таблетке «Нолицина» перед выездом, а затем продолжают курс по одной таблетке в день до завершения похода. Общая продолжительность приема данного антибиотика не должна превышать 3 недель.
«Нолицин» назначают также пациентам с нейтропеническими состояниями, когда целью является предупреждение развития септических осложнений. В такой ситуации этот антибиотик врачи прописывают по 800 миллиграмм в день, разделяя на два приема. Курс проводят до восьми недель. Отзывы о «Нолицине» при цистите также представлены.
Чтобы предупредить обострение инфекции мочевыводящих путей, препарат назначают в дозе 200 миллиграмм раз в сутки.
Продолжительность лечения в данном случае устанавливается лечащим врачом и напрямую зависит от частоты рецидивов. Если есть необходимость, то длительность приема антибиотика может составить до полугода.
Корректировку назначенной дозы у лиц с заболеваниями почек проводят в зависимости от клиренса креатинина в организме.
Побочные эффекты от употребления
Нежелательными эффектами от использования «Нолицина», по отзывам, могут стать различные расстройства со стороны органов пищеварения диспепсического характера, которые будут сопровождаться горечью во рту, болями в животе, а также антибиотикоассоциированной диареей. Помимо этого, пациенты могут столкнуться с псевдомембранозным колитом, молочницей и дисбактериозом.

Кроме того, вероятно увеличение объема трансаминаз печени, которое может установить биохимический анализ крови. В случае малого употребления жидкости может возникнуть кристалурия. Такое явление, как гломерулонефриты, на фоне приема «Нолицина» формируется крайне редко.
Часто встречающимся осложнением, которое развивается на фоне лечения любыми фторхинолонами, служит фотосенсибилизация. В связи с этим во время проведения терапии рекомендуется всячески избегать инсоляции, а также применять изделия с высоким уровнем содержания солнцезащитных фильтров.
На фоне длительного приема вероятно воспаление сухожилий, а также их разрыв. При этом чаще всего повреждается ахиллово сухожилие. К тому же возможны реакции аллергического типа наряду с нарушениями сердечного ритма, артериальной гипотензией, судорогами, тремором конечностей, а также тревожностью и бессонницей.
Отзывы о «Нолицине»
Отзывы врачей о «Нолицине», который больным назначают при инфекциях пищеварительных органов и мочеполовой системы, как правило, положительные. Специалисты не раз успели убедиться на практике, что данный антибиотик является мощным средством, которое обладает высокой эффективностью.
Правда, подобно всем фторхинолонам, он достаточно трудно переносится пациентами, так как обладает значительным количеством нежелательных эффектов, а также противопоказаний к использованию.
Доктора пишут, что чаще всего назначают «Нолицин» пациентам, страдающим циститом. Они сообщают, что этот препарат прекрасно справляется с данным заболеванием, в том числе с его хроническими формами.
Кроме того, врачи рассказывают, что антибиотик весьма эффективен и довольно быстро способен купировать все основные симптомы заболевания, в особенности когда речь идет о болевом синдроме и частых мочеиспусканиях.
Какие еще есть о «Нолицине» отзывы?
Из недостатков данного лекарственного средства врачи отмечают различные побочные эффекты, которые наблюдаются у их пациентов в результате приема препарата. Самыми частыми симптомами специалисты называют тошноту, молочницу, сонливость, головные боли, бессонницу, наличие горечи во рту, диарею и спутанность сознания, а иногда воспаление сухожилий.

Стоимость
За упаковку препарата придется отдать 180-220 рублей. Аналоги можно найти дешевле.
Аналоги
К ним можно отнести «Норбактин», «Нормакс», «Локсон-400», «Норфлоксацин». Данные лекарственные средства считаются структурными аналогами по действующему веществу.
Заключение
В заключение стоит сказать, что на сегодняшний день врачи называют «Нолицин» одним из медикаментов выбора в случае появления воспалительных недугов мочевыделительной системы.
Таким образом, это лекарственное средство признано специалистами сильным, а главное, эффективным, но, как и любой другой антибиотик, может назначаться только по рекомендации врача.
Самолечение этим препаратом недопустимо.
Мы рассмотрели инструкцию по применению, цену, отзывы, аналоги.
Цена «Нолицина» зависит от региона и от аптечной сети.
Нолицин
Нолицин – это противомикробное средство из группы фторхинолов, которое обладает достаточно широким спектром действия. Имеет бактерицидное свойство. Угнетает действие бактериальной ДНК-гиразы, тем самым препятствуя ее размножению.
Благодаря нарушению синтеза белков микроорганизмов, приводит к их гибели. Применяется в борьбе с большинством грамотрицательных бактерий (сальмонелла, шигелла, протеус, морганелла, энтеровирус…) и с некоторыми грамположительными (стафилококк в том числе).
В этой статье мы рассмотрим для чего врачи назначают Нолицин, в том числе инструкцию по применению, аналоги и цены на это лекарственное средство в аптеках. Реальные ОТЗЫВЫ людей которые уже воспользовались Нолицин можно прочитать в х.
Форма выпуска и состав
Выпускается в таблетках, покрытых пленочной оболочкой: круглых, слегка двояковыпуклых, оранжевого цвета, с риской на одной из сторон (в блистерах по 10 шт., по 1 или 2 блистера в картонной пачке).
- Активное вещество – норфлоксацин: в 1 таблетке – 400 мг.
- Дополнительные компоненты: карбоксиметилкрахмал натрия, магния стеарат, кремния диоксид коллоидный безводный, целлюлоза микрокристаллическая, повидон, вода очищенная.
Клинико-фармакологическая группа: антибактериальный препарат группы фторхинолонов.
Нолицин: показания к применению
Таблетки Нолицин показаны к применению пациентам для лечения следующих патологических состояний и их осложнений:
- Воспалительные процессы органов половой системы – воспаление шейки матки и цервикального канала, воспаление слизистой оболочки матки, воспаление предстательной железы у мужчин бактериального происхождения;
- Воспалительные заболевания органов мочевыводящей системы – воспаление мочеточников, мочевого пузыря, почек, мочеиспускательного канала;
- Воспаление слизистых оболочек пищеварительного канала (желудка и кишечника) бактериального происхождения – сальмонеллез, шигеллез;
- Профилактика развития сепсиса у пациентов с нейтропенией;
- Лечение гонореи.
Препарат назначают для профилактики рецидивов хронических воспалительных заболеваний органов мочевыделения;
Также показан в качестве профилактического средства для предотвращения диареи путешественника.

Фармакологическое действие
Противомикробный препарат группы фторхинолонов широкого спектра действия. Механизм действия норфлоксацина связан с подавлением фермента ДНК-гиразы в клетках микроорганизмов, вследствие чего предотвращается синтез ДНК бактерий.
К препарату чувствительны Staphylococcus aureus (включая штаммы Staphylococcus spp., резистентные к метициллину), Staphylococcus epidermidis, Neisseria gonorrhoeae, Neisseria meningitidis, Escherichia coli, Citrobacter spp., Klebsiella spp., Enterobacter spp.
, Hafhia alvei, Proteus spp. (индол-положительные и индол-отрицательные штаммы), Salmonella spp., Shigella spp., Yersinia enterocolitica, Campylobacter jejuni, Aeromonas spp., Plesiomonas spp., Vibrio cholerae, Vibrio parahaemolyticus, Haemophilus influenzae, Chlamydia spp.
, Legionella spp.
Длительность противомикробного действия — около 12 ч. Период полувыведения активного компонента препарата Нолицин составляет 3-4 часа. У пациентов с нарушением функций почек возможно некоторое изменение фармакокинетических показателей норфлоксацина.
Инструкция по применению
Согласно инструкции по применению Нолицин принимают внутрь, запивая жидкостью в достаточном количестве, предпочтительнее – натощак (соблюдая интервалы: не меньше 1 часа до либо через 2 часа после еды).
- При остром неосложненном цистите — по 400 мг 2 раза/сут в течение 3-5 дней.
- При хроническом бактериальном простатите — по 400 мг 2 раза/сут в течение 4-6 недель или более.
- При бактериальном гастроэнтерите (шигеллез, сальмонеллез) — по 400 мг 2 раза/сут в течение 5 дней.
- При неосложненной гонорее — однократно в дозе 800-1200 мг или по 400 мг 2 раза/сут в течение 3-7 дней.
- Для профилактики сепсиса при нейтропении — по 400 мг 2 раза/сут в течение 8 недель.
- Для профилактики рецидивирующих неосложненных инфекций мочевыводящих путей при частых обострениях (более 3 эпизодов в год или более 2 в течение полугода) — по 200 мг 1 раз на ночь длительно (от 6 мес до нескольких лет).Для профилактики диареи путешественников рекомендуется принимать по 400 мг/сут за 1 день до отъезда, в течение всего времени путешествия и 2 дня после его окончания (не более 21 дня).
Усредененно-рекомендуемые дозы препарата — по 400 мг 2 раза/сут. Продолжительность лечения от 7 до 14 дней, при необходимости проводят более длительную терапию.
Противопоказания
Противопоказаниями к приему Нолицина являются:
- Подростковый возраст до 18 лет.
- Гиперчувствительность к норфлоксацину и иным препаратам группы фторхинолонов.
- Период беременности и грудного вскармливания.
- Дефицит глюкозо-6-фосфатдегидрогеназы.
Нолицин назначается с особой осторожностью при атеросклерозе сосудов головного мозга, эпилепсии, нарушении мозгового кровообращения, эпилептическом синдроме, аллергии на ацетилсалициловую кислоту, почечной или печеночной недостаточности.
Побочные действия
К побочным эффектам при лечении Нолицином относят:
- Аллергические реакции: сыпь, крапивница, синдром Стивенса-Джонсона, отёки.
- Со стороны органов ЖКТ (желудочно-кишечного тракта): горечь во рту, тошнота, рвота, диарея.
- Со стороны органов кроветворения: эозинофилия (повышение эозинофилов), лейкопения (снижение лейкоцитов).
- Со стороны центральной нервной системы: обморок, головокружение, головная боль, галлюцинации, нарушения сна, раздражительность.
- Со стороны мочеполовой системы: дизурия (нарушения мочеиспускания), кровотечения, гломерулонефрит.
- Со стороны сердечно-сосудистой системы: аритмия, гипотония (низкое давление), тахикардия.

Беременность и лактация
Безопасность применения при беременности и в период лактации (грудного вскармливания) не изучена.
Назначать Нолицин при беременности следует только по жизненным показаниям, когда предполагаемая польза для матери превышает потенциальный риск для плода.
При необходимости назначения препарата в период лактации следует прекратить грудное вскармливание.
Аналоги Нолицина
Структурными аналогами (синонимами) Нолицина, включающими одно и то же действующее вещество – норфлоксацин – являются:
- Норилет;
- Норбактин;
- Норфацин;
- Софазин;
- Глюренорм;
- Локсон-400;
- Нормакс;
- Депренорм;
- Нороксин;
- Норфлоксацин;
- Чиброксин;
- Ренор;
- Ютибид.
Внимание: применение аналогов должно быть согласовано с лечащим врачом.
Цены
Средняя цена НОЛИЦИН в аптеках (Москва) 170 рублей.
Условия отпуска из аптек
Препарат отпускается по рецепту.
От чего помогает «Нолицин». Инструкция, отзывы и цена таблеток
Рубрика: н Опубликовано 28.07.2017 · Комментарии: 1 ·
На чтение: 4 мин ·
Просмотры:
Эффективное антибактериальное лекарственное средство — это «Нолицин». Инструкция по применению предлагает принимать антибиотик при инфекционно-воспалительных заболеваниях мочеполовой системы, в частности цистита. Таблетки относят к группе фторхинолонов.

Форма выпуска и состав
Лекарственная форма выпуска препарата «Нолицин» – это таблетки, покрытые пленочной оболочкой: оранжевые, круглые, несколько двояковыпуклые, на одной стороне – с риской (по 10 шт. в блистерах, по 1 или 2 блистера в картонной пачке). В состав 1 таблетки входит: активное вещество — норфлоксацин в объеме 400 мг.
Фармакологические свойства
Лекарство «Нолицин» — это противомикробный препарат группы фторхинолонов широкого спектра действия. Оказывает бактерицидное действие. Воздействует на бактериальный фермент ДНК-гиразу, обеспечивающую сверхспирализацию и, таким образом, стабильность ДНК бактерий. Дестабилизация цепи ДНК приводит к гибели бактерий.
Обладает широким спектром антибактериального действия. К препарату «Нолицин», инструкция по применению сообщает об этом, чувствительны Staphylococcus aureus (включая штаммы Staphylococcus spp.
, резистентные к метициллину), Staphylococcus epidermidis, Neisseria gonorrhoeae, Neisseria meningitidis, Escherichia coli, Citrobacter spp., Klebsiella spp., Enterobacter spp., Hafhia alvei, Proteus spp. (индол-положительные и индол-отрицательные штаммы), Salmonella spp., Shigella spp.
, Yersinia enterocolitica, Campylobacter jejuni, Aeromonas spp., Plesiomonas spp., Vibrio cholerae, Vibrio parahaemolyticus, Haemophilus influenzae, Chlamydia spp., Legionella spp.
Различной чувствительностью к препарату обладают: Enterococcus faecalis, Streptococcus spp. (Streptococcus pyogenes, Streptococcus pneumoniae и Streptococcus viridans), Serratia marcescens, Pseudomonas aeruginosa, Acinetobacter spp., Mycoplasma hominis, Mycoplasma pneumoniae, Mycobacterium tuberculosis, Mycobacterium fortuitum. Длительность противомикробного действия — около 12 ч.
Таблетки «Нолицин»: от чего помогает лекарство, когда назначают
Показания к применению включают патологии мочеполовой системы инфекционно-воспалительного характера:
- цервицит;
- хронически протекающий простатит бактериального генеза;
- уретрит;
- эндометрит;
- неосложненная форма гонореи;
- цистит;
- пиелонефрит.
Для чего «Нолицин» назначают еще?
- сальмонеллез;
- бактериальный гастроэнтерит;
- шигеллез.
Дополнительные показания к применению таблеток: предупреждение диареи путешественника и профилактика септических осложнений у пациентов с нейтропенией.
Препарат «Нолицин»: инструкция по применению и дозирование
Препарат предназначен для перорального применения. Таблетки следует пить за 1 час до или спустя 2 часа после трапезы, запивая достаточным количеством воды. Рекомендуемая доза «Нолицина» — 400 мг 2 раза в день. Длительность лечения составляет от 7 до 14 дней. В случае необходимости больному могут назначить более продолжительную терапию.
При неосложненной гонорее оптимальная однократная доза препарата – 800–1200 мг или по 400 мг 2 раза в день на протяжении 3–7 дней. При бактериальном простатите хронического течения пациенту следует принимать по 400 мг «Нолицина» 2 раза в день на протяжении 4–6 недель или более.
При бактериальном гастроэнтерите (сальмонеллез, шигеллез) — по 400 мг 2 раза в день сроком до 5 дней. При остром неосложненном цистите препарат принимают в дозе по 400 мг 2 раза в день на протяжении 3–5 дней. Для профилактики сепсиса у пациентов с нейтропенией назначают по 400 мг 2 раза в день в течение 8 недель.
Для профилактики диареи путешественников «Нолицин» используется в дозе по 400 мг в день за 1 день до отъезда, затем на протяжении всего времени путешествия и 2 дня после его завершения (но не больше 21 дня).
Для профилактики инфекций мочевыводящих путей при постоянных обострениях (более 2 эпизодов в течение полугода или 3 эпизодов в год) принимают по 200 мг 1 раз в день (на ночь) сроком от 6 месяцев до нескольких лет.
Людям с функциональными нарушениями почек коррекция режима дозирования не нужна. Пациентам, которые находятся на гемодиализе, и больным с почечной недостаточностью прописывают половину разовой терапевтической дозы «Нолицина» 2 раза в день или полную дозу 1 раз в день.
Побочное действие
- отеки;
- снижение АД;
- головокружение;
- депрессия;
- гломерулонефрит;
- разрывы сухожилий (обычно в случае комбинации со способствующими факторами);
- злокачественная экссудативная эритема (синдром Стивенса-Джонсона);
- псевдомембранозный энтероколит (при длительном применении);
- галлюцинации;
- головная боль;
- бессонница;
- тошнота, рвота;
- диарея;
- снижение аппетита;
- сыпь;
- эозинофилия, лейкопения, снижение гематокрита;
- раздражительность;
- кожный зуд;
- усталость;
- васкулит;
- уретральные кровотечения;
- крапивница;
- полиурия;
- кандидоз;
- чувство страха;
- шум в ушах;
- тахикардия;
- аритмии;
- боль в животе;
- беспокойство;
- обморочные состояния;
- сонливость;
- повышение мочевины и креатинина плазмы крови;
- горечь во рту.
Противопоказания
Абсолютные:
- Дефицит глюкозо-6-фосфатдегидрогеназы.
- Возраст до 18 лет.
- Гиперчувствительность к компонентам препарата «Нолицин», от чего таблетки могут вызвать аллергию.
- Беременность и период лактации (беременным женщинам назначение «Нолицин»а возможно только по жизненным показаниям, если ожидаемая польза для здоровья женщины выше возможного риска для плода).
Относительные («Нолицин» назначается с осторожностью на фоне следующих заболеваний и состояний):
- Наличие аллергической реакции на ацетилсалициловую кислоту.
- Нарушения мозгового кровообращения.
- Эпилепсия и эпилептический синдром.
- Печеночная или почечная недостаточность.
- Атеросклероз сосудов головного мозга.
Аналоги лекарства «Нолицин»
Полные аналоги по активному компоненту:
- Норфлоксацин.
- Норфацин.
- Нормакс.
- Локсон-400.
- Чиброксин.
- Ютибид.
- Нороксин.
- Норбактин.
- Софазин.
- Ренор.
- Норилет.
Цена
В аптеках Москвы цена таблеток «Нолицин» 400 мг составляет 195 рублей. В минске антибиотик стоит 10 — 14 бел. рублей. В Киеве препарат можно купить за 250 гривен, в Казахстане — за 780 тенге.
Отзывы
О лечении посредством «Нолицина» цистита отзывы пациентов исключительно положительные. Препарат достаточно быстро купирует все неприятные симптомы заболевания (частое мочеиспускание, болевой синдром). «Нолицин» – недорогой и эффективный антибиотик от цистита. Только лечащий врач может назначить лекарственное средство и объяснить, как принимать.
Таблетки 400 мг Нолицин: инструкция, цена и отзывы

Форма выпуска и состав
Нолицин выпускается в форме таблеток, покрытых пленочной оболочкой, предназначенных для приема внутрь. Таблетки упакованы в блистеры по 10 штук, по 1 или 2 блистера в картонной пачке с прилагающимся подробным описанием.
Каждая таблетка препарата содержит в себе активное действующее вещество – Норфлоксацин в дозе 400 мг.
Фармакологическое действие
Нолицин инструкция по применению относит к антибактериальным препаратам широкого спектра действия. Дополнительно он оказывает противомикробный и бактерицидный эффект.
Микроорганизмы, чувствительные к препарату: Staphylococcus aureus (включая штаммы Staphylococcus spp., резистентные к метициллину), Staphylococcus epidermidis, Neisseria gonorrhoeae, Neisseria meningitidis, Escherichia coli, Citrobacter spp., Klebsiella spp., Enterobacter spp.
, Hafhia alvei, Proteus spp. (индол-положительные и индол-отрицательные штаммы), Salmonella spp., Shigella spp., Yersinia enterocolitica, Campylobacter jejuni, Aeromonas spp., Plesiomonas spp., Vibrio cholerae, Vibrio parahaemolyticus, Haemophilus influenzae, Chlamydia spp.
, Legionella spp.
Различной чувствительностью к препарату обладают: Enterococcus faecalis, Streptococcus spp. (Streptococcus pyogenes, Streptococcus pneumoniae и Streptococcus viridans), Serratia marcescens, Pseudomonas aeruginosa, Acinetobacter spp., Mycoplasma hominis, Mycoplasma pneumoniae, Mycobacterium tuberculosis, Mycobacterium fortuitum.
От чего помогает Нолицин (таблетки)?
Показания к применению лекарства включают заболевания мочеполовой системы инфекционно-воспалительного характера:
- эндометрит;
- неосложненная форма гонореи;
- уретрит;
- цервицит;
- пиелонефрит;
- цистит;
- хронически протекающий простатит бактериального генеза.
От чего еще может быть назначен Нолицин: бактериальный гастроэнтерит, шигеллез, сальмонеллез. Дополнительные показания к применению таблеток: предупреждение диареи путешественника и профилактика септических осложнений у пациентов с нейтропенией.
Инструкция по применению
Нолицин принимают внутрь, натощак (не менее чем за 1 ч до или через 2 ч после приема пищи) и запивают достаточным количеством жидкости. Рекомендуемые дозы — по 400 мг 2 раза в сутки. Продолжительность лечения от 7 до 14 дней, при необходимости проводят более длительное лечение.
- Для профилактики сепсиса при нейтропении — по 400 мг 2 раза в сутки в течение 8 недель.
- При неосложненной гонорее — однократно в дозе 800-1200 мг или по 400 мг 2 раза в сутки в течение 3-7 дней.
- При бактериальном гастроэнтерите (шигеллез, сальмонеллез) — по 400 мг 2 раза в сутки в течение 5 дней.
- Для профилактики рецидивирующих неосложненных инфекций мочевыводящих путей при частых обострениях (более 3-х эпизодов в год или более 2-х в течение полугода) — по 200 мг 1 раз на ночь длительно (от 6 месяцев до нескольких лет).
- При остром неосложненном цистите — по 400 мг 2 раза в сутки в течение 3-5 дней.
- Для профилактики диареи путешественников рекомендуется принимать по 400 мг в сутки за 1 день до отъезда, в течение всего времени путешествия и 2 дня после его окончания (не более 21 дня).
- При хроническом бактериальном простатите — по 400 мг 2 раза в сутки. в течение 4-6 недель или более.
Противопоказания
Препарат можно принимать только по назначению врача, самолечение может привести к серьезным негативным последствиям. Перед началом лечения следует ознакомиться с прилагающейся инструкцией. Таблетки противопоказаны при наличии следующих состояний:
- Печеночная или почечная недостаточность.
- Индивидуальная непереносимость норфлоксацина или любого из входящих в состав компонентов.
- Беременность и период кормления малыша грудью.
- Возраст до 18 лет, так как клинический опыт применения отсутствует, а безопасность лекарства для детей и подростков не доказана.
К относительным противопоказаниям относятся:
- Индивидуальная непереносимость ацетилсалициловой кислоты.
- Атеросклеротические отложения на стенках кровеносных сосудов головного мозга.
- Эпилепсия.
- Нарушения мозгового кровообращения.
- Побочные явления
- Пищеварительная система: рвота, понижение аппетита, тошнота, горечь во рту, боли в животе, диарея, псевдомембранозный энтероколит (при продолжительной терапии), повышение активности печеночных трансаминаз.
- Мочевыделительная система: гломерулонефрит, альбуминурия, кристаллурия, полиурия, дизурия, уретральные кровотечения, повышение креатинина и мочевины плазмы крови.
- Скелетно-мышечная система: тендиниты, артралгия, разрывы сухожилий (как правило, на фоне способствующих этому факторов).
- Нервная система: галлюцинации, головная боль, обморочные состояния, головокружение, бессонница; у пожилых больных – раздражительность, чувство страха, усталость, беспокойство, сонливость, шум в ушах, депрессия.
- Сердечно-сосудистая система: васкулит, аритмии, тахикардия, снижение артериального давления.
- Аллергические реакции: кожный зуд, сыпь, отеки, крапивница, злокачественная экссудативная эритема (синдром Стивенса-Джонсона).
- Кроветворная система: понижение гематокрита, лейкопения, эозинофилия.
- Другие: кандидоз.
Детям, при беременности и кормлении грудью
Нолицин во время беременности назначается лишь в том случае, если польза для матери выше потенциальных рисков для плода. При необходимости пройти лечение во время лактации грудное вскармливание рекомендуется прекратить.
Согласно инструкции, Нолицин противопоказан детям и подросткам, не достигшим возраста 18 лет.
Особые указания
- Во время приема препарата Нолицин важно увеличить употребление жидкости, контролируя при этом суточный диурез.
- В период терапии препаратом следует избегать длительного нахождения под прямыми солнечными лучами и посещения соляриев, так как под воздействием лекарства у пациентов увеличивается риск развития фотосенсибилизации.
- Лицам, которые плохо переносят ацетилсалициловую кислоту, следует быть осторожными, так как при приеме таблеток Нолицин может развиваться тяжелый бронхоспазм.
- Так как препарат влияет на работу центральной нервной системы, то в период применения таблеток следует избегать вождения автомобиля или управления сложными механизмами, требующими повышенной концентрации внимания.
Лекарственное взаимодействие
Медикамент снижает эффективность нитрофуранов, повышает концентрацию циклоспорина (взаимное действие) и непрямых антикоагулянтов. Норфлоксацин снижает общий клиренс теофиллина на 1/4.
При одновременной терапии с медикаментами, которые снижают эпилептический порог, могут усилиться эпилептиформные припадки. Антацидные средства снижают всасываемость Нолицина.
При приеме гипотензивных средств регистрируется резкое падение кровяного давления. Применение медикаментов для общей анестезии требует обязательного контроля над частотой пульса, цифрами артериального давления, работой сердца (ЭКГ).
Аналоги лекарства Нолицин
По структуре определяют аналоги:
- Ренор.
- Софазин.
- Норилет.
- Локсон-400.
- Чиброксин.
- Нороксин.
- Нормакс.
- Норбактин.
- Ютибид.
- Норфацин.
- Норфлоксацин.
Условия отпуска и цена
Средняя цена Нолицин (таблетки 400 мг №10) в Москве составляет 176 рублей. Препарат отпускается в аптеках по рецепту врача.
Таблетки следует хранить в сухом, прохладном, недоступном для детей месте сроком не более 5 лет от даты, обозначенной на упаковке.
Нолицин: инструкция по применению и для чего он нужен, цена, отзывы, аналоги

Нолицин – это антибактериальное лекарственное средство из группы фторхинолонов. Назначается при острых, хронических инфекциях мочеполового тракта. Препарат противопоказан в детском возрасте, в период вынашивания плода и кормления грудью.
Лекарственная форма
Нолицин выпускается в виде таблеток для перорльного (через рот) применения. Таблетки круглой двояковыпуклой формы, имеют пленочную оболочку, оранжевого цвета, с фаской с одной стороны для деления дозировки пополам. Препарат расфасован в ячейки из ПВХ, по 1 или 2 блистера в картонной упаковке, № 10 или № 20.
Описание и состав
Действующее вещество лекарственного средства – норфлоксацин (400 мг). Препарат представляет собой антибактериальное средство из группы фторхинолонов. Норфлоксацин активен в отношении большинства штаммов грамотрицательных бактерий, некоторых штаммов грамположительных бактерий. К лекарственному средству резистентны анаэробные микроорганизмы и стрептококки.
Вспомогательные вещества: целлюлоза, диоксид кремния, повидон, стеарат магния, крахмал, тальк, пропиленгликоль, краситель желтый закат.
Фармакологическая группа
Нолицин относится к антимикробным лекарственным средствам. Фармакологическая группа – антибиотики широкого спектра действия, фторхинолоны. Препарат оказывает бактерицидное действие на грамотрицательные и грамположительные бактерии, в том числе активен в отношении микроорганизмов, которые синтезируют бета-лактамазу.
Фармакодинамика
Норфлоксацин – активное вещество в составе Нолицина, представляет собой антибиотик широкого спектра действия из группы фторхинолонов. Препарат обладает бактерицидным действием в отношении:
- грамотрицательных бактерий: Escherichia coli, Salmonella spp., Shigella spp., Proteus spp., Morganella morganii, Klebsiella spp., Enterobacter spp., Serratia marcescens, Citrobacter spp., Yersinia enterocolitica, Providencia spp., Haemophilus influenzae, Pseudomonas aeruginosa.;
- грамположительных бактерий: Staphylococcus spp., бактерии, продуцирующие бета-лактамазу;
- Acinetobacter spp. и Enterococcus spp.
Норфлоксацин угнетает функцию ДНК-гиразы – фермента, который способствует удвоению ДНК патогенных бактерий. В результате нарушается деление клеток микроорганизмов, блокируется синтез белков, ДНК разрушается не фрагменты и бактерии погибают. Широкий спектр действия препарата позволяет назначать его при большинстве инфекционно-воспалительных заболеваний мочевыделительной системы.
Фармакокинетика
Лекарственное средство на 40 % всасывается в пищеварительном тракте после приема внутрь. Пиковую концентрацию норфлоксацина в крови наблюдают через час после поступления препарата в желудок. В крови норфлоксацин связывается с транспортными белками крови. Проникает в ткани организма, в первую очередь, мочевыделительной и половой системы. Период полувыведения составляет 3-4 часа.
Лекарственное средство частично метаболизируется в печени с образованием активных метаболитов. Препарат выводится в основном с мочой, в меньшей степени с калом. Фармакологическая активность норфлоксацина не зависит от показателей рН мочи.
Показания к применению
Для взрослых
Нолицин назначают при острых, хронических, рецидивирующих инфекциях мочеполовой системы, вызванных патогенной микрофлорой, чувствительной к препарату.
- Острый и хронический пиелонефрит.
- Острый и хронический пиелит.
- Острый и хронический простатит.
- Острый и хронический цистит.
- Нефролитиаз.
- Нейрогенный мочевой пузырь, осложненный инфицированием патогенной микрофлорой.
- Рецидивирующие формы инфекционно-воспалительных заболеваний нижних отдела мочевого тракта.
Лекарственное средство применяют для профилактики инфицирования мочевыделительной системы после хирургического вмешательства на органах малого таза или диагностических инвазивных процедур. Препарат назначают для предупреждения развития диареи путешественников (поездки в экзотические страны).
Для детей
Нолицин не применяется для терапии в детском возрасте.
Для беременных и в период лактации
Не проводилось клинических испытаний по изучению влияния препарата на внутриутробное развитие плода и состояние новорожденного на грудном вскармливании.
Есть данные о разрушающем действии норфлоксацина на хрящевую ткань плода и грудного ребенка. Нолицин не назначают во время беременности и лактации.
Применение лекарственного средства в период грудного вскармливания требует временного перевода ребенка на искусственные смеси.
Противопоказания
Перед назначением лекарственного средства доктор учитывает противопоказания для предупреждения развития нежелательных эффектов терапии.
- Индивидуальная непереносимость активного и вспомогательного вещества в составе препарата.
- Аллергическая реакция на применение фторхинолонов в анамнезе.
- Период вынашивания плода.
- Период грудного вскармливания.
Применение Нолицина в редких случаях может вызвать воспаление и разрыв сухожилий. Патология опорно-двигательного аппарат в анамнезе на фоне приема антибиотиков фторхинолового ряда – противопоказание к назначению препарата.
Применение и дозы
Для взрослых
Нолицин принимают между приемами пищи – за 60 минут до еды или 120 минут после еды. Таблетки запивают небольшим количеством воды, глотают целиком.
При острых инфекциях мочевыводящих путей назначают по 400 мг (1 таблетка) 2 раза в сутки. Курс терапии 5-10 дней в зависимости от тяжести заболевания. При хронической рецидивирующей патологии мочевого тракта назначают по 400 мг (1 таблетка) 2 раза в сутки. Курс лечения 4-12 недель в зависимости от тяжести течения болезни.
При инфицировании половых органов, в том числе гонококковой инфекцией, назначают по 400-800 грамм (1-2 таблетки) 2 раз в сутки. Для профилактики постоперационного инфицирования мочевыводящих путей и диареи путешественников назначают по 400 мг (1 таблетка) 1-2 раза в сутки.
Для детей
В детском возрасте Нолицин не применяют.
Для беременных и в период лактации
В эмбриональный период и во время грудного вскармливания Нолицин не назначают.
Побочные действия
Побочные эффекты развиваются редко, проходят самостоятельно в первые дни терапии. Риск развития побочного действия препарат повышается при назначении высоких терапевтических доз и длительном курсе лечения.
- Головная боль, головокружение.
- Раздражительность, бессонница.
- Галлюцинации.
- Депрессивные состояния.
- Тошнота, редко рвота.
- Послабление стула.
- Шум в ушах.
- Спутанность сознания.
- Аллергическая сыпь, зуд кожи.
- Воспаление (тенденит) и разрыв сухожилий.
В крови наблюдают повышение концентрации печеночных ферментов, лейкопению, эозинофилию, креатинемию.
Взаимодействие с другими лекарственными средствами
В случае одновременного назначения Нолицина и циклоспорина, варфарина, теофиллиа усиливается фармакологическое действие лекарственных веществ. Применение норфлоксацина на фоне терапии нитрофурантоином уменьшает терапевтический эффект препаратов.
Антациды, препарат железа и цинка снижают абсорбцию Нолицина в пищеварительном тракте. Назначение с гипокликемическими лекарственными средствами усиливает сахароснижающий эффект.
Хинолоны и глюкокортикостероиды при параллельном лечении с норфлоксацином увеличивают риск поражения сухожилий.
Особые указания
Нолицин с осторожностью применяют для терапии пациентов с почечной и печеночной недостаточностью, эпилепсией и судорожным синдромом в анамнезе. Норфлоксацин снижает протромбиновый индекс, что требует контроля показателей свертывающей системы крови, особенно перед оперативными вмешательствами.
В редких случаях препарат может вызвать псевдомембранозный колит, что требует замены лекарственного средства. Нолицин при длительном применении способствует фотосенсибилизации организма. Во время терапии необходимо ограничивать время пребывания на солнце.
Молочные продукты нарушают абсорбцию лекарственного препарата в желудке. Между употреблением этих продуктов в пищу и Нолицина должно пройти не менее 2 часов. То же самое касается препаратов, в состав которых входит железо и цинк.
Лекарственное средство может снижать скорость психомоторной реакции при управлении транспортными средствами и работе с опасными механизмами.
Передозировка
При передозировке препарата возникает тошнота, рвота, послабление стула, головокружение, спутанность сознания, в тяжелых случаях наступает кома. Необходимо промыть желудок, назначить энтерсорбенты и симптоматическую терапию. Снизить интоксикацию организма помогает форсированный диурез.
Условия хранения
Лекарственное средство необходимо хранить при температуре не выше +25 градусов, в сухом и темном месте. Ограничить доступ детей к препарату.
Аналоги
Вместо Нолицина можно применять следующие препараты:
- Нормакс является полным аналогом Нолицина. В продаже лекарство бывает в таблетках, ушных и глазных каплях. Нормакс противопоказан лицам до 18 лет, женщинам, оживающим ребенка. Применение медикамента несовместимо с естественным вскармливанием.
- Норбактин — индийский препарат, содержащий норфлоксацин. Производится он в таблетках, которые запрещены для лечения детей, беременных и кормящих.
- Абактал является заменителем Нолицина по клинико-фармакологической группе. Выпускается он в виде концентрата для изготовления раствора для внутривенного введения и таблетках. Абактал нельзя лицам моложе 18 лет, во время вынашивания плода и естественного вскармливания.
- Глево является заменителем Нолицина по терапевтической группе. Это противомикробное средство из группы фторхинолонов, которое производится в таблетках и растворе для инфузий. Глево запрещено назначать детям, противопоказан он и на протяжении всей беременности и лактации.
Цена препарата
Стоимость лекарственного средства составляет в среднем 281 рубль. Цены колеблются от 144 до 490 рублей.
Таблетки Нолицин — показания к применению
Самый эффективный способ лечения бактериальных инфекций основан на проведении антибактериальной терапии. Для этого пациентам часто назначают препараты из группы фторхинолонов, одним из которых является Нолицин.
Фармакологическое действие
Нолицин — антибактериальный препарат, проявляющий эффективность в отношении:
- большинства грамотрицательных бактерий (шигелл, клебсиелл, энтеробактерий, сальмонелл и пр.);
- некоторых грамположительных бактерий (например, стафилококков).
В связи с этим Нолицин относится к бактерицидным средствам широкого спектра действия. Его активный компонент разрушает ДНК-цепочки бактерий и нарушает тем самым у них выработку белков. Это приводит к уничтожению микробов и ускорению выздоровления пациента.
К лекарству обрели резистентность стрептококки и анаэробные микроорганизмы, поэтому оно не помогает при лечении инфекций, вызванных этими микробами.
Полностью оно покидает организм через 24 часа.
Препарат быстро всасывается и начинает действовать спустя 20-30 минут после приема. Эффект от его применения достигает своего пика через 2-3 часа после применения и поддерживается на терапевтическом уровне на протяжении 12 часов. Действующее вещество выводится через почки и кишечник, частично проникает в грудное молоко.
Состав и форма выпуска
Нолицин выпускается в виде таблеток, покрытых плёночной оболочкой. Главным его компонентом выступает норфлоксацин. В каждой таблетке содержится 0,4 г этого вещества. В состав также входят:
- повидон;
- стеариновокислый магний;
- вода дистиллированная;
- гипромеллоза;
- краситель Е110;
- краситель Е171;
- кремниевая двуокись;
- натриевая соль гликолята крахмала;
- микрокристаллическая целлюлоза;
- консервант Е1520.
Таблетки имеют круглую и двояковыпуклую форму. Они покрыты пленочной оболочкой оранжевого цвета. На одной из сторон есть риска.
Показания и противопоказания
Таблетки Нолицин помогают от инфекций, вызванных бактериями, проявляющих чувствительность к этому препарату. Для них определены следующие показания:
- инфекции почек и мочевыводящих путей (циститы, нефриты, уретриты);
- инфекции пищеварительного тракта (колиты, энтериты);
- инфекция, вызванная гонококками;
- диарея путешественников;
- инфекции репродуктивной системы как у женщин, так и у мужчин (эндометриты, простатиты);
- профилактика заражения крови у людей с пониженным содержанием нейтрофилов.
Нолицин назначают только взрослым. Безопасность и эффективность его применения у детей не доказаны, поэтому средство не применяют для лечения пациентов в возрасте до 18 лет. Так как фторхинолоны повышают риск развития врожденных аномалий, средство противопоказано при беременности. А из-за проникновения активного компонента в молоко лекарство также нельзя принимать кормящим матерям.
[media=https://youtu.be/52UjaLJov5Q]
Как правильно принимать Нолицин — инструкция
Дозировку определяет лечащий врач в зависимости от поставленного диагноза, тяжести болезни и наличия/отсутствия осложнений. Общие рекомендации следующие:
- при инфекциях органов репродуктивной системы — по 400-600 мг 2 раза в день;
- для предупреждения диареи путешественников и рецидивов хронического цистита/пиелонефрита — 400 мг 1 раз в сутки;
- для лечения гонококковой инфекции — 800 мг однократно;
- для профилактики сепсиса — 400 мг 3 раза в день;
- в остальных случаях — 400 мг дважды в сутки.
Препарат следует принимать натощак (за 60 минут до еды или через 120 минут после нее). Таблетки нужно проглатывать целыми, запивая их большим количеством воды или другой жидкости. Если вы пропустили прием, примите пропущенную дозу, а прием следующей немного сдвиньте. Если прошло слишком много времени, продолжите курс лечения по схеме так, будто вы ничего не пропускали.
Продолжительность лечения острых инфекций ЖКТ, половых органов, почек и мочевыводящих путей составляет от 3 до 10 суток. Профилактическая терапия может продолжаться до 4-12 недель. При гонококковой инфекции лекарство пьют однократно.
Возможные побочные эффекты
После применения Нолицина могут развиться следующие нежелательные симптомы:
- тошнота;
- потеря аппетита;
- нарушения стула (понос);
- головная боль и головокружение;
- сонливость и повышение утомляемости;
- затуманивание сознания и галлюцинации;
- появление чувства страха, беспокойства, звона в ушах;
- повышение раздражительности;
- впадение в депрессию;
- воспаление и/или разрыв сухожилий (очень редко);
- анафилактический шок;
- кожные высыпания и зуд.
Активный компонент средства влияет на систему кроветворения, в результате чего может изменить состав крови. При клиническом анализе возможно выявление повышение содержания эозинофилов. При этом концентрация красных кровяных телец и лейкоцитов уменьшается.
Условия отпуска из аптек, производитель и примерная стоимость
Примерные цены на препарат в Тихвине (Ленинградская область):
- Упаковка (10 таблеток) стоит около 153 руб.
- Упаковка (20 таблеток) стоит около 303 руб.
Отпускается Нолицин в руки пациента по рецепту врача. Страна производства — Словения (фирма КРКА). Хранить его следует при температуре не выше +20 оС в месте, недоступном для детей. Срок годности составляет 5 лет с момента производства.
Чем можно заменить
У препарата есть множество аналогов по составу. Он также может быть заменен другими средствами с похожим фармакологическим действием. Выясним, какие лекарства могут быть назначены вместо Нолицина, и сколько они стоят.
| Торговое название | Активный компонент | Производитель | Цена |
| Норбактин | Норфлоксацин. | Ранбакси Лабораториз Лимитед (Индия). | В упаковке таблеток:
|
| Нормакс | Ипка (Индия). | Упаковка (6 таблеток) — около 142 р. | |
| Норфлоксацин | Оболенское ФП (Россия). | В упаковке таблеток:
|
|
| Лебел | Левофлоксацин. | Nobel Ilac Sanayii ve Ticaret A.S. (Турция). | Упаковка (7 таблеток) — около 356 р. |
| Флексид | Lek (Словения). | В упаковке таблеток: 5 шт. — от 251 р. 14 шт. — от 721 р. | |
| Авелокс | Моксифлоксацин. | Bayer Pharma AG (Германия). | В упаковке:
|
Нолицин — антибактериальный препарат, эффективный в отношении большинства патогенных бактерий, которые часто становятся причиной развития инфекций. Однако после его применения у пациентов нередко проявляются побочные эффекты. Поэтому следует строго соблюдать рекомендации врача и принимать лекарство согласно схеме. Тогда риск развития нежелательных симптомов будет минимальным.
i Пожалуйста оцените статью, мы старались: